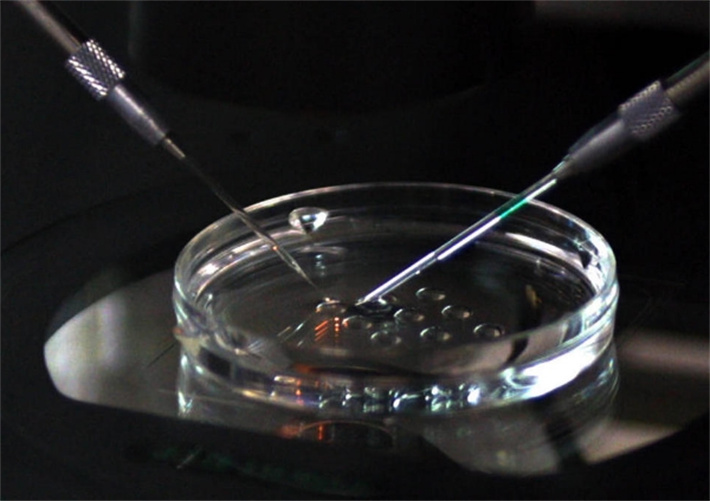
icsi

在选择海外试管婴儿时,技术常常是大家关注的焦点。在众多的医学术语中,您可能听过“ICSI”(卵胞浆内单精子注射)。而现在,这项经典技术有了一个更精细的升级版——PIEZO-ICSI。它正在成为日本试管婴儿医院的常规选择。

简单来说,PIEZO-ICSI的核心是让受精这个过程,变得更温和、更精准。它就像把一台精密仪器的操作,从“手动模式”升级到了“微创自动模式”。
ICSI与PIEZO-ICSI的区别
ICSI即用一根非常尖细的注射针,直接“推”开卵子外层的保护膜(透明带和细胞膜),把精子送进去。这个过程有点像用一根细针去刺一个充满液体的气球。为了刺穿,针需要施加一定的机械力,这会让卵子形状发生挤压和变形。

而PIEZO-ICSI,换了一种思路。它的注射针头是平口的,并不依靠“硬推”。取而代之的,是应用超音振动(压电脉冲)技术。针尖通过极细微、高频的振动,在卵子保护膜上“震动”出一个小孔。这个过程非常迅速,卵子几乎不发生形变,像用一把轻柔的“振动钥匙”打开门锁,而不是用力推开门。
PIEZO-ICSI有什么好处?
这种操作方式的不同,带来了实实在在的好处,尤其是在保护卵子和提升后续结果方面:
1.对卵子的物理损伤更小

免了直接的机械穿刺和挤压,大程度地保护了卵子内部精细的细胞结构。这对于那些本身质量就较为脆弱(比如高龄取得的卵子)的卵子来说,尤为关键。
2.可能获得更高的受精率与更优质的胚胎

因为减少了对卵子的干扰,卵子能保持更好的状态去完成受精和后续分裂。一些临床观察发现,采用这种方法后,卵子的正常受精率、发育成优质囊胚的比例都有所提升。这意味着,可用的、有潜力的胚胎可能会更多。
3.操作更精准稳定
超音振动打孔的位置可以更灵活,不局限于正中心。这让操作医生在避开卵子内部重要结构(如纺锤体)时更有余地,进一步提升了安全性。
谁可能更适合考虑这项技术?
虽然PIEZO-ICSI是一项进步,但并非人人都必须选择。它更像是一件为特定情况准备的“精密工具”。在以下情况中,它的优势可能会体现得更加明显:

1.女方年龄较大,预计卵子质量相对脆弱。
2.既往采用传统ICSI受精后,结果不理想(如受精率低、胚胎发育差)。
3.卵巢储备功能减退,可获得的卵子数量本身就很少,需要极致呵护每一颗。
在锦欣国际合作的日本试管婴儿医院,PIEZO-ICSI成为其精细化胚胎实验室操作的一部分。它代表了辅助生殖技术向着更轻柔、更尊重卵子本身生理状态的发展方向。

当您在了解海外试管婴儿方案时,知道有这样一项技术存在,可以成为一个具体的问题去和您的医生探讨:“根据我的情况,是否适用PIEZO-ICSI这类更精细的受精方式?”与主治医生进行基于技术的深入沟通,本身就是迈向成功的重要一步。
在您了解诸如PIEZO-ICSI等技术信息后,若需进一步探索海外试管婴儿的相关流程,锦欣国际可提供专业的跨境咨询服务。我们的服务聚焦于非医疗领域,包括协助梳理不同目的地的技术特点、提供流程信息及行程规划参考。锦欣国际的目标是成为您的信息顾问,帮助您更清晰地规划和面对跨境就医旅程。

电话:400-0776-521
地址:北京市丰台区丽泽路24号平安幸福中心
微信扫码咨询
微信VIP客服





